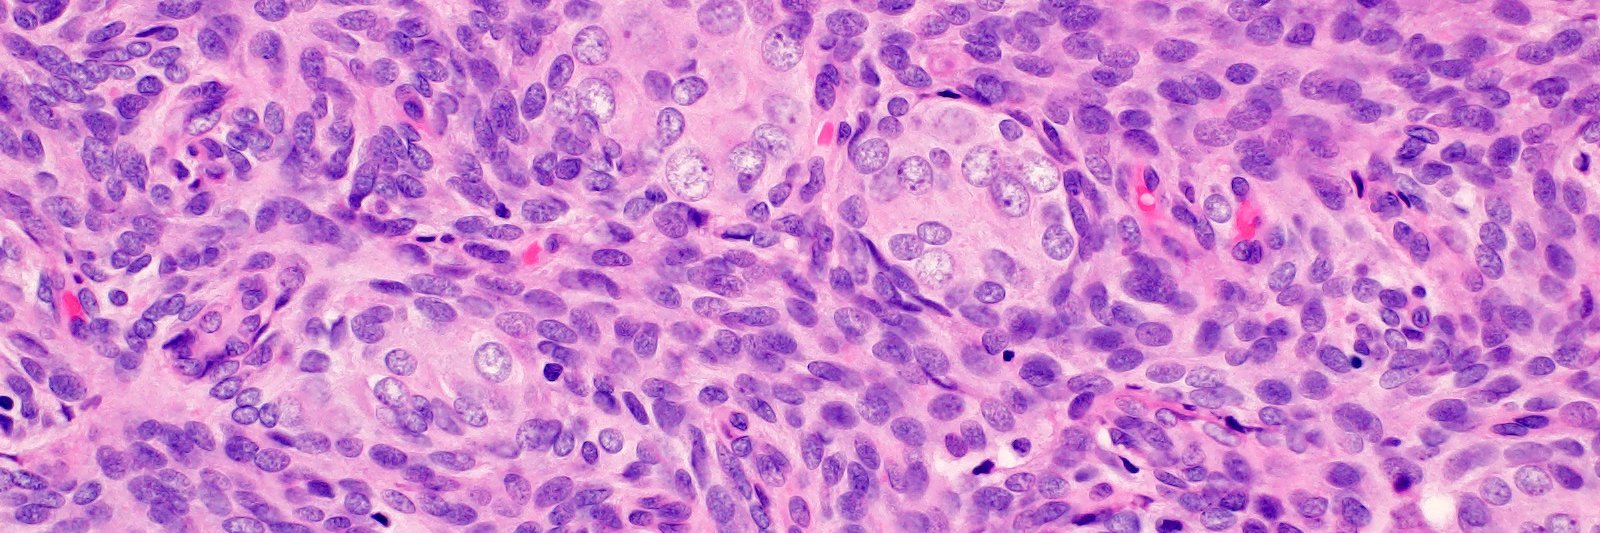
Brooke E. Howitt banner

Brooke E. Howitt
202 posts

Brooke E. Howitt
@BrookeHowittMD
Gynecologic and Soft Tissue Pathologist at Stanford. I also dabble in GU :-) Full time mommy to two busy toddlers. 👨🏼🤝👨🏻. Occasionally I run 🏃♀️
Stanford, CA Katılım Mart 2009
269 Takip Edilen810 Takipçiler
Brooke E. Howitt retweetledi

This study was led by three talented members of my lab @christineyyeh , Karmen Aguirre, and Olivia Laveroni, and in collaboration with @BrookeHowittMD. A big thank you to all lab members and co-authors, Mike Bassik, Sylvia Katina Plevritis, and @SnyderShot. (14/15)
English
Brooke E. Howitt retweetledi

Came back from long Twitter slumber to share our critic of the new FIGO staging system for endometrial cancer. Made freely available by the @IGCSociety at
ijgc.bmj.com/content/early/…
Happy read!
English
Brooke E. Howitt retweetledi
Brooke E. Howitt retweetledi

Professor Glenn McCluggage MBE - Congratulations⭐️🙌⭐️ #BAGP
English
Brooke E. Howitt retweetledi

Massive thanks for all of the speakers and delegates for making our #19thAnnualMeeting a great success! #BAGP #SurgPath #PathTwitter #gynaepath #pathology


English
Brooke E. Howitt retweetledi

Dr Lucy Grant delivering a case presentation on squamous cell carcinomas of the uterus at the 19th Annual Meeting #BAGP #SurgPath #PathTwitter #gynaepath #pathology


English

Really fun chance to informally discuss our recent publications with Tjalling. 🍻
The British Assoc of Gynaecological Pathology@BAGPGynPath
By the pathologists, of the pathologists - podcast style interviews at the BAGP 19th Annual Meeting 2023 #BAGP #SurgPath #PathTwitter #gynaepath #pathology
English
Brooke E. Howitt retweetledi

Professor Glenn McCluggage starts the second day of the hybrid 19’th Annual BAGP meeting with a talk on practical approach to mucinous tumours of the ovary #BAGP #SurgPath #PathTwitter #gynaepath #pathology

English
Brooke E. Howitt retweetledi

Associate Professor Brooke Howitt delivering a lecture on the practical approach to sex cord stromal tumours of the ovary #BAGP #SurgPath #PathTwitter #gynaepath #pathology


English
Brooke E. Howitt retweetledi

Professor Tjalling Bosse presenting on the practical approach to vulval epithelial lesions #BAGP #SurgPath #PathTwitter #gynaepath #pathology


English

Thank you so much for having me again on the podcast- always a pleasure! 😊
George J. Netto MD@DrNetto
COMING SOON! Our latest ModPath CHAT podcast with Dr. Brook Howitt from Stanford University as we discuss her team’s recent study on PTEN expression in Tubo-Ovarian High-Grade Serous Carcinoma (HGSCs). @TheUSCAP @ModernPathology @uabmedicine @PennPathLabMed @UABPathology @StanfordPath @PennMedicine
English
Brooke E. Howitt retweetledi

An absolutely beautiful Syndicate talk by @LivnatJerby from @Stanford on geospatial mapping in ovarian cancer, cell-cell interactions, and the importance of location! Tremendous potential for collaboration. @BrookeHowittMD Great turn out too (85)! @BasserBRCA @shenhui1986 @penn


English
Brooke E. Howitt retweetledi

19th Annual Meeting of the BAGP is being held on 8, 9 June 2023 in London. This will be a hybrid event & delegates can select virtual or in person participation. Early bird offer is currently available. Follow this link to book thebagp.org/event/the-brit…

English
Brooke E. Howitt retweetledi

I love all my children equally but WHOA do we have a treat for you! Please join us tomorrow morning @ 11 ET for our next ISIMM webinar: a #gynpath extravaganza.
@AnneMillsMD: MMR/PD-L1
@BrookeHowittMD: mesenchymal tumors
Jaclyn Watkins: vulvar pathology
Matt Quick: endometrium




English
Brooke E. Howitt retweetledi

Very grateful for another #uscap meeting. Learned from and interacted with many of my favorite people. Those entering the #pathology family tomorrow with the #Match2023 have lots to look forward to! Can't think of doing anything else for a living




English
Brooke E. Howitt retweetledi


Congratulations @PhoebeHammerMD @StanfordPath and Xiaoming Zhang! 👏🏼 I feel so lucky to work with such fantastic trainees.
International Society of Gynecologic Pathologists@ISGynP
Congratulations to trainees receiving the @ISGynP awards at the #USCAP2023 Annual Meeting!
English

I love these people. Two #gynpath stars of my generation and dear friends @BrookeHowittMD & Matt Quick #USCAP2023

English




